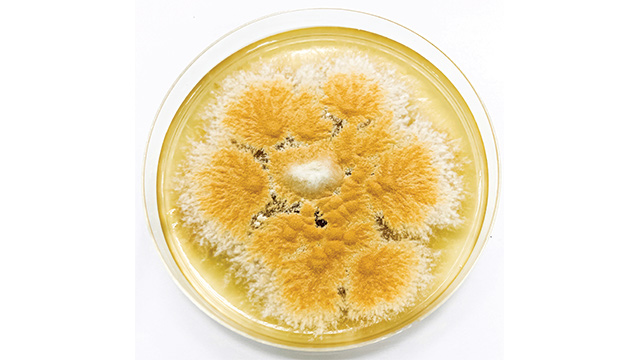

Фотографии Microporum gypseum















.jpg)









































.jpg)

Раздел: Природная галерея